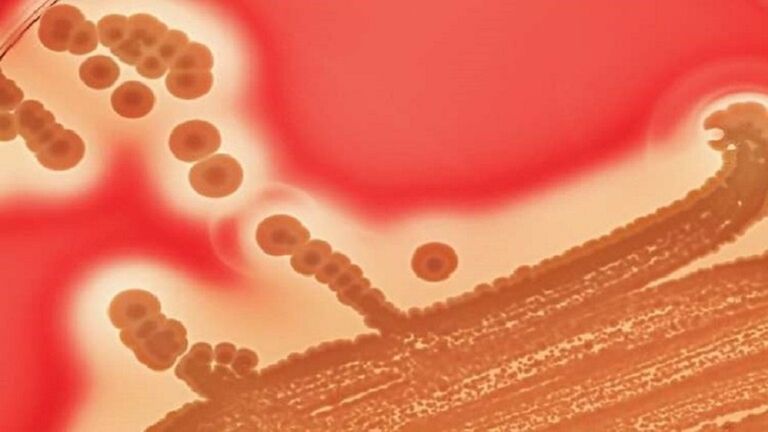
يابانيون يتجولون في أحد الشوارع

«تآكل الجسم وفشل الأعضاء».. انتشار مرض خطير في اليابان
تزايد عدد مرضى متلازمة الصدمة السامة للمكورات العقدية (STSS)، التي تسبب "تآكل الجسم"، التي باتت تنتشر بوتيرة قياسية في اليابان.
ومتلازمة STSS عدوى قاتلة تحدث نتيجة الإصابة بالبكتيريا المسببة لالتهاب الحلق العقدي، ويمكن أن تسبب فشل أعضاء متعددة ونخر الأطراف، ويبلغ معدل وفياتها نحو 30% من المصابين بسبب نخر الأنسجة وفشل أعضاء الجسم.
ويتم اكتشاف سلالات معدية بشكل خاص في كثير من الأحيان، ويدعو الخبراء إلى زيادة الوعي، وخاصة بين كبار السن، الذين هم أكثر عرضة للإصابة بالعدوى.
وتعمل وزارة الصحة على تعزيز جهود المراقبة، لكن العلاقة بين السلالة وارتفاع حالات الإصابة بمتلازمة STSS غير واضحة، وفقا لموقع japantimes.
لكن العلماء يشيرون إلى أن زيادة العدوى قد تكون مرتبطة برفع التدابير التقييدية التي تم تطبيقها خلال جائحة "كوفيد-19".
وقال البروفيسور كين كيكوتشي، من مستشفى جامعة طوكيو الطبية النسائية: "يشكل كبار السن الذين تبلغ أعمارهم 65 عامًا فما فوق غالبية مرضى STSS، وغالبًا ما تدخل البكتيريا من خلال إصابات طفيفة في القدم مثل تقرحات الأحذية والطفح الجلدي الناجم عن قدم الرياضي".
ويوصي الخبراء للحماية من العدوى المحتملة بضرورة الاهتمام بالنظافة الشخصية وغسل اليدين بانتظام وارتداء الكمامات الواقية في الأماكن العامة.
ووفقا لبيانات المعهد الوطني الياباني للأمراض المعدية، بلغ عدد المصابين بهذا المرض منذ بداية عام 2024 وحتى 5 مايو/أيار الجاري نحو 801، أي ما يزيد بمقدار 2.76 مرة مقارنة بنفس الفترة من عام 2023.
ما هي متلازمة STSS؟
تحدث متلازمة STSS نتيجة الإصابة بالمكورات العقدية من المجموعة А، التي تنتقل في المقام الأول عن طريق الاتصال البشري والقطرات المحمولة جوا.
وغالبًا ما يظل الأشخاص المصابون بدون أعراض، لكن يمكن للبكتيريا أن تتسلل إلى الدم والأنسجة مثل العضلات، ما يؤدي أحيانًا إلى الإصابة بـ STSS.
وتشمل الأعراض الأولية الحمى والقشعريرة، ويمكن أن تتطور العدوى بسرعة لتسبب حالة من الصدمة من خلال انخفاض ضغط الدم وفشل العديد من الأعضاء.
وتشمل أنواع البكتيريا العقدية المجموعة (أ) والمجموعة (ب) والمجموعة (ز)، ومن الصعب تشخيص STSS في مراحله المبكرة، وغالبًا ما يتطلب تطور الأعراض إجراء تقييم دقيق.
لذا، هناك حاجة إلى استجابات فورية عندما تتورم أقدام المرضى بسرعة ويصابون بحمى تصل إلى 39 درجة مئوية أو أعلى.
aXA6IDIxNi43My4yMTYuMTAzIA==
جزيرة ام اند امز